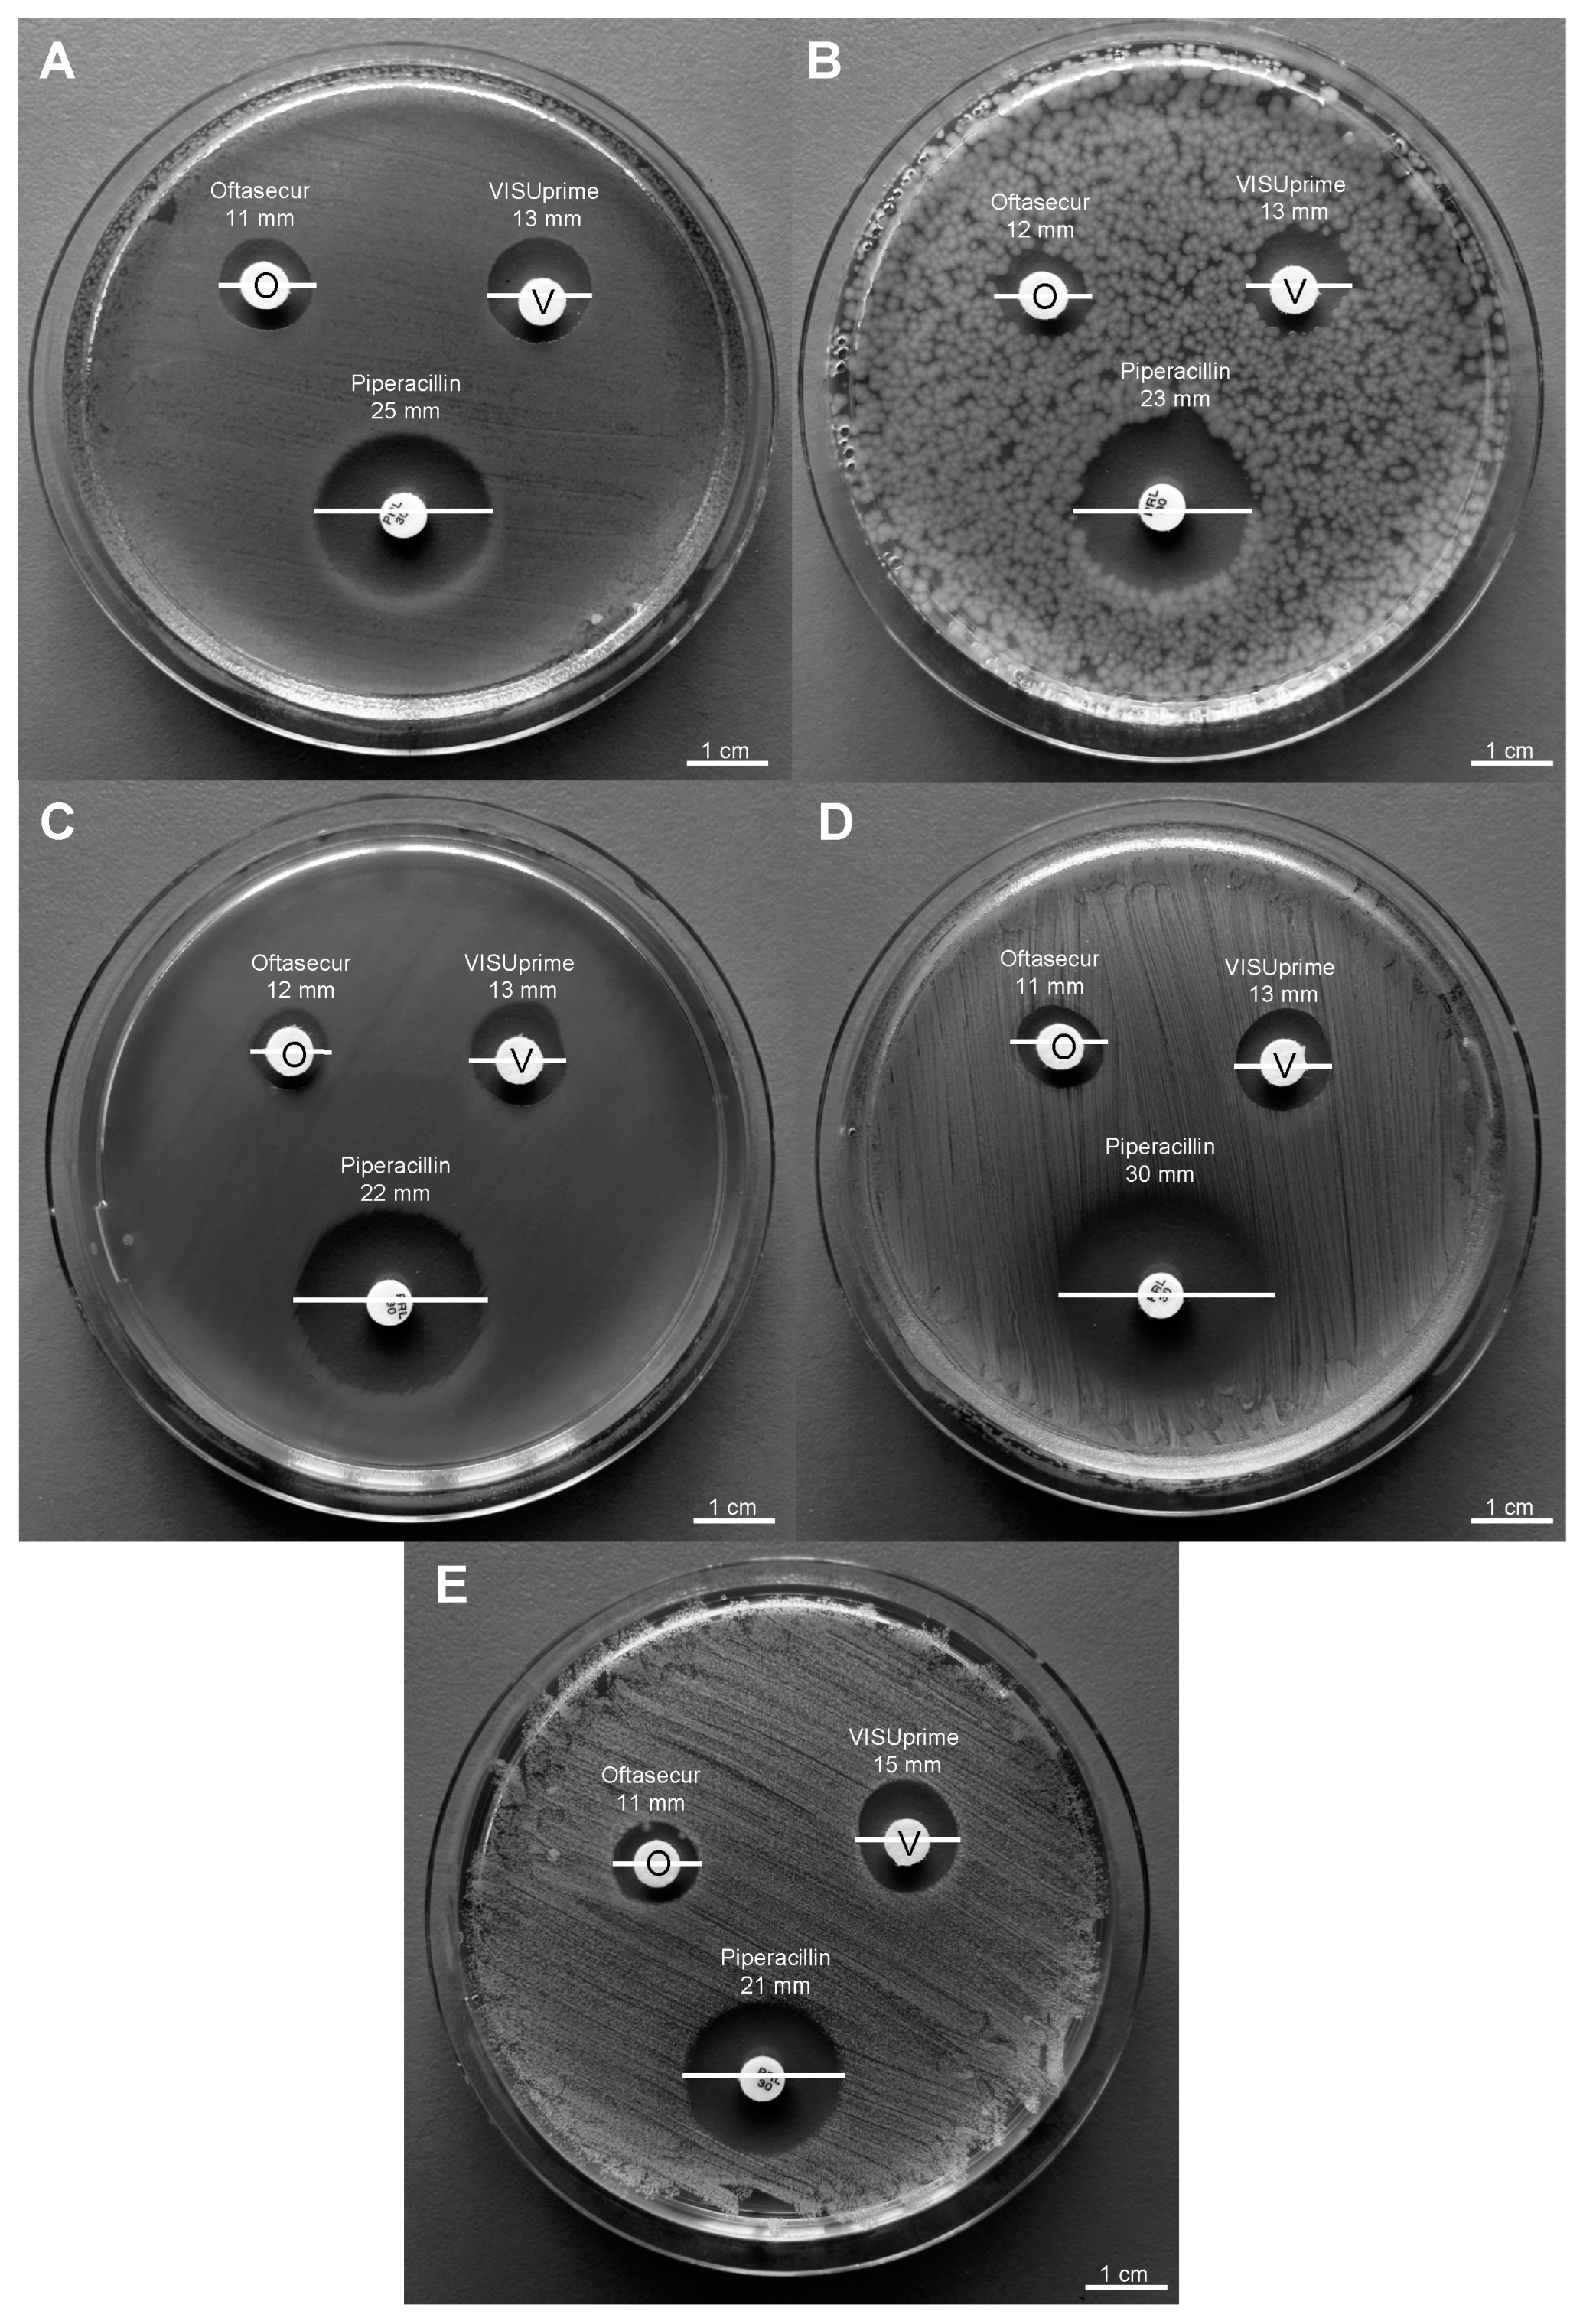
Microorganisms 11 00503 g002 Microorganisms 11 00503 g002

Broad-Spectrum Antimicrobial Activity of Oftasecur and Visuprime Ophthalmic Solutions
Abstract
1. Introduction
2. Materials and Methods
2.1. Ophthalmic Solutions
2.2. Bacteria and Growth Conditions
2.3. Cell Culture Conditions
2.4. Viruses and Propagation
2.5. Cell Cytotoxicity Test
2.6. Disk Diffusion Test
2.7. Antibacterial Susceptibility Assays
2.8. Bacterial Killing Kinetic Tests
2.9. Plaque Assay
2.10. Real-Time Molecular Analysis
2.11. Statistical Analyses
3. Results
3.1. Cytotoxic Activity
3.2. Antibacterial Activity
3.3. Antiviral Activity
3.4. Molecular Investigation of UL27 and UL54
4. Discussion
Author Contributions
Funding
Institutional Review Board Statement
Informed Consent Statement
Data Availability Statement
Conflicts of Interest
References
- Azari, A.A.; Arabi, A. Conjunctivitis: A Systematic Review. J. Ophthalmic Vis. Res. 2020, 15, 372–395. [Google Scholar] [CrossRef] [PubMed]
- Hashmi, M.F.; Gurnani, B.; Benson, S. Conjunctivitis. In StatPearls; StatPearls Publishing: Treasure Island, FL, USA, 2022. [Google Scholar]
- Shekhawat, N.S.; Shtein, R.M.; Blachley, T.S.; Stein, J.D. Antibiotic Prescription Fills for Acute Conjunctivitis among Enrollees in a Large United States Managed Care Network. Ophthalmology 2017, 124, 1099–1107. [Google Scholar] [CrossRef] [PubMed]
- Pepose, J.S.; Sarda, S.P.; Cheng, W.Y.; McCormick, N.; Cheung, H.C.; Bobbili, P.; Joseph, C.; Duh, M.S. Direct and Indirect Costs of Infectious Conjunctivitis in a Commercially Insured Population in the United States. Clin. Ophthalmol. 2020, 14, 377–387. [Google Scholar] [CrossRef] [PubMed]
- Bernell, S.; Howard, S.W. Use Your Words Carefully: What Is a Chronic Disease? Front. Public Health 2016, 4, 159. [Google Scholar] [CrossRef] [PubMed]
- Hope, P.K.F.; Lynen, L.; Mensah, B.; Appiah, F.; Kamau, E.M.; Ashubwe-Jalemba, J.; Boaitey, K.P.; Adomako, L.A.B.; Alaverdyan, S.; Appiah-Thompson, B.L.; et al. Appropriateness of Antibiotic Prescribing for Acute Conjunctivitis: A Cross-Sectional Study at a Specialist Eye Hospital in Ghana, 2021. Int. J. Environ. Res. Public Health 2022, 19, 11723. [Google Scholar] [CrossRef]
- Ho, D.; Lim, S.; Kim Teck, Y. Pseudomembranous Conjunctivitis: A Possible Conjunctival Foreign Body Aetiology. Cureus 2020, 12, e8176. [Google Scholar] [CrossRef]
- O’Gallagher, M.; Bunce, C.; Hingorani, M.; Larkin, F.; Tuft, S.; Dahlmann-Noor, A. Topical Treatments for Blepharokeratoconjunctivitis in Children. Cochrane Database Syst. Rev. 2017, 2, CD011965. [Google Scholar] [CrossRef]
- Addis, H.; Jeng, B.H. Vernal Keratoconjunctivitis. Clin. Ophthalmol. 2018, 12, 119–123. [Google Scholar] [CrossRef]
- Yeu, E.; Hauswirth, S. A Review of the Differential Diagnosis of Acute Infectious Conjunctivitis: Implications for Treatment and Management. Clin. Ophthalmol. 2020, 14, 805–813. [Google Scholar] [CrossRef]
- Ahuja, A.S.; Farford, B.A.; Forouhi, M.; Abdin, R.; Salinas, M. The Ocular Manifestations of COVID-19 Through Conjunctivitis. Cureus 2020, 12, e12218. [Google Scholar] [CrossRef]
- Caruso, C.; Eletto, D.; Tosco, A.; Pannetta, M.; Scarinci, F.; Troisi, M.; Porta, A. Comparative Evaluation of Antimicrobial, Antiamoebic, and Antiviral Efficacy of Ophthalmic Formulations. Microorganisms 2022, 10, 1156. [Google Scholar] [CrossRef]
- Azari, A.A.; Barney, N.P. Conjunctivitis: A Systematic Review of Diagnosis and Treatment. JAMA 2013, 310, 1721–1729. [Google Scholar] [CrossRef]
- Troisi, M.; Zannella, C.; Troisi, S.; De Bernardo, M.; Galdiero, M.; Franci, G.; Rosa, N. Ocular Surface Infection by SARS-CoV-2 in COVID-19 Pneumonia Patients Admitted to Sub-Intensive Unit: Preliminary Results. Microorganisms 2022, 10, 347. [Google Scholar] [CrossRef] [PubMed]
- Petrillo, F.; Petrillo, A.; Marrapodi, M.; Capristo, C.; Gicchino, M.F.; Montaldo, P.; Caredda, E.; Reibaldi, M.; Boatti, L.M.V.; Dell’Annunziata, F.; et al. Characterization and Comparison of Ocular Surface Microbiome in Newborns. Microorganisms 2022, 10, 1390. [Google Scholar] [CrossRef] [PubMed]
- Belser, J.A.; Rota, P.A.; Tumpey, T.M. Ocular Tropism of Respiratory Viruses. Microbiol. Mol. Biol. Rev. 2013, 77, 144–156. [Google Scholar] [CrossRef]
- Belser, J.A.; Gustin, K.M.; Maines, T.R.; Pantin-Jackwood, M.J.; Katz, J.M.; Tumpey, T.M. Influenza Virus Respiratory Infection and Transmission Following Ocular Inoculation in Ferrets. PLoS Pathog. 2012, 8, e1002569. [Google Scholar] [CrossRef] [PubMed]
- Solano, D.; Fu, L.; Czyz, C.N. Viral Conjunctivitis. In StatPearls; StatPearls Publishing: Treasure Island, FL, USA, 2022. [Google Scholar]
- Madurapandian, Y.; Rubeshkumar, P.; Raju, M.; Janane, A.; Ganeshkumar, P.; Selvavinayagam, T.S.; Kaur, P. Case Report: An Outbreak of Viral Conjunctivitis among the Students and Staff of Visually Impaired School, Tamil Nadu, India, 2020. Front. Public Health 2022, 10, 978200. [Google Scholar] [CrossRef]
- Pippin, M.M.; Le, J.K. Bacterial Conjunctivitis. In StatPearls; StatPearls Publishing: Treasure Island, FL, USA, 2022. [Google Scholar]
- Teweldemedhin, M.; Gebreyesus, H.; Atsbaha, A.H.; Asgedom, S.W.; Saravanan, M. Bacterial Profile of Ocular Infections: A Systematic Review. BMC Ophthalmol. 2017, 17, 212. [Google Scholar] [CrossRef]
- Visscher, K.L.; Hutnik, C.M.L.; Thomas, M. Evidence-Based Treatment of Acute Infective Conjunctivitis: Breaking the Cycle of Antibiotic Prescribing. Can. Fam. Physician 2009, 55, 1071–1075. [Google Scholar]
- Burrell, C.J.; Howard, C.R.; Murphy, F.A. Laboratory Diagnosis of Virus Diseases. In Fenner and White’s Medical Virology; Elsevier: Amsterdam, The Netherlands, 2017; pp. 135–154. ISBN 978-0-12-375156-0. [Google Scholar]
- van Weert, H.C.P.M.; Tellegen, E.; Ter Riet, G. A New Diagnostic Index for Bacterial Conjunctivitis in Primary Care. A Re-Derivation Study. Eur. J. Gen. Pract. 2014, 20, 202–208. [Google Scholar] [CrossRef]
- Terreni, M.; Taccani, M.; Pregnolato, M. New Antibiotics for Multidrug-Resistant Bacterial Strains: Latest Research Developments and Future Perspectives. Molecules 2021, 26, 2671. [Google Scholar] [CrossRef]
- Gupta, N.; Vashist, P.; Tandon, R.; Gupta, S.K.; Kalaivani, M.; Dwivedi, S.N. Use of Traditional Eye Medicine and Self-Medication in Rural India: A Population-Based Study. PLoS ONE 2017, 12, e0183461. [Google Scholar] [CrossRef]
- McDonnell, G.; Russell, A.D. Antiseptics and Disinfectants: Activity, Action, and Resistance. Clin. Microbiol. Rev. 1999, 12, 147–179. [Google Scholar] [CrossRef]
- Ali, F.S.; Jenkins, T.L.; Boparai, R.S.; Obeid, A.; Ryan, M.E.; Wibblesman, T.D.; Chiang, A.; Garg, S.J. Post-Injection Endophthalmitis Study Group Aqueous Chlorhexidine Compared with Povidone-Iodine as Ocular Antisepsis before Intravitreal Injection: A Randomized Clinical Trial. Ophthalmol. Retin. 2021, 5, 788–796. [Google Scholar] [CrossRef]
- Pedrotti, E.; Bonacci, E.; Kilian, R.; Pagnacco, C.; Fasolo, A.; Anastasi, M.; Manzini, G.; Bosello, F.; Marchini, G. The Role of Topical Povidone-Iodine in the Management of Infectious Keratitis: A Pilot Study. J. Clin. Med. 2022, 11, 848. [Google Scholar] [CrossRef]
- Eggers, M. Infectious Disease Management and Control with Povidone Iodine. Infect. Dis. Ther. 2019, 8, 581–593. [Google Scholar] [CrossRef]
- Dell’Annunziata, F.; Sellitto, C.; Franci, G.; Marcotullio, M.C.; Piovan, A.; Della Marca, R.; Folliero, V.; Galdiero, M.; Filippelli, A.; Conti, V.; et al. Antiviral Activity of Ficus Rubiginosa Leaf Extracts against HSV-1, HCoV-229E and PV-1. Viruses 2022, 14, 2257. [Google Scholar] [CrossRef]
- Aramă, V. Topical Antibiotic Therapy in Eye Infections—Myths and Certainties in the Era of Bacterial Resistance to Antibiotics. Rom. J. Ophthalmol. 2020, 64, 245–260. [Google Scholar] [CrossRef]
- Mencucci, R.; Ghelardi, E.; Celandroni, F.; Mazzantini, C.; Vecchione, A.; Pellegrini-Giampietro, D.E.; Favuzza, E.; Landucci, E. Antiseptics and the Ocular Surface: In Vitro Antimicrobial Activity and Effects on Conjunctival and Corneal Epithelial Cells of a New Liposomal Ocular Spray Containing Biosecur® Citrus Extract. Ophthalmol. Ther. 2022, 11, 1067–1077. [Google Scholar] [CrossRef]
- Cormier, J.; Scott, R.; Janes, M. Antibacterial Activity of Biosecur(®) Citrus Extract Surface Cleaner against Vibrio Vulnificus. Open Microbiol. J. 2013, 7, 130–134. [Google Scholar] [CrossRef]
- De Nova, P.J.G.; Carvajal, A.; Prieto, M.; Rubio, P. In Vitro Susceptibility and Evaluation of Techniques for Understanding the Mode of Action of a Promising Non-Antibiotic Citrus Fruit Extract Against Several Pathogens. Front. Microbiol. 2019, 10, 884. [Google Scholar] [CrossRef]
- Codling, C.E. Aspects of the Antimicrobial Mechanisms of Action of a Polyquaternium and an Amidoamine. J. Antimicrob. Chemother. 2003, 51, 1153–1158. [Google Scholar] [CrossRef]
- Ziklo, N.; Bibi, M.; Salama, P. The Antimicrobial Mode of Action of Maltol and Its Synergistic Efficacy with Selected Cationic Surfactants. Cosmetics 2021, 8, 86. [Google Scholar] [CrossRef]
- Xie, Y.; Yang, W.; Tang, F.; Chen, X.; Ren, L. Antibacterial Activities of Flavonoids: Structure-Activity Relationship and Mechanism. CMC 2014, 22, 132–149. [Google Scholar] [CrossRef]
- Yuan, G.; Guan, Y.; Yi, H.; Lai, S.; Sun, Y.; Cao, S. Antibacterial Activity and Mechanism of Plant Flavonoids to Gram-Positive Bacteria Predicted from Their Lipophilicities. Sci. Rep. 2021, 11, 10471. [Google Scholar] [CrossRef]
- Jiao, Y.; Niu, L.-N.; Ma, S.; Li, J.; Tay, F.R.; Chen, J.-H. Quaternary Ammonium-Based Biomedical Materials: State-of-the-Art, Toxicological Aspects and Antimicrobial Resistance. Prog. Polym. Sci. 2017, 71, 53–90. [Google Scholar] [CrossRef]
- Rohan, L.C.; Ratner, D.; McCullough, K.; Hiller, S.L.; Gupta, P. Measurement of Anti-HIV Activity of Marketed Vaginal Products and Excipients Using a PBMC-Based In Vitro Assay. Sex. Transm. Dis. 2004, 31, 143–148. [Google Scholar] [CrossRef]
- Macinga, D.R.; Sattar, S.A.; Jaykus, L.-A.; Arbogast, J.W. Improved Inactivation of Nonenveloped Enteric Viruses and Their Surrogates by a Novel Alcohol-Based Hand Sanitizer. Appl. Environ. Microbiol. 2008, 74, 5047–5052. [Google Scholar] [CrossRef]
- Torky, Z.A.; Hossain, M.M. Pharmacological Evaluation of the Hibiscus Herbal Extract Against Herpes Simplex Virus-Type 1 as an Antiviral Drug in Vitro. Int. J. Virol. 2017, 13, 68–79. [Google Scholar] [CrossRef]
- Yi, L.; Li, Z.; Yuan, K.; Qu, X.; Chen, J.; Wang, G.; Zhang, H.; Luo, H.; Zhu, L.; Jiang, P.; et al. Small Molecules Blocking the Entry of Severe Acute Respiratory Syndrome Coronavirus into Host Cells. J. Virol. 2004, 78, 11334–11339. [Google Scholar] [CrossRef]
- Pollock, S.; Nichita, N.B.; Böhmer, A.; Radulescu, C.; Dwek, R.A.; Zitzmann, N. Polyunsaturated Liposomes Are Antiviral against Hepatitis B and C Viruses and HIV by Decreasing Cholesterol Levels in Infected Cells. Proc. Natl. Acad. Sci. USA 2010, 107, 17176–17181. [Google Scholar] [CrossRef] [PubMed]
- Aryan, H.; Saxena, A.; Tiwari, A. Correlation between Bioactive Lipids and Novel Coronavirus: Constructive Role of Biolipids in Curbing Infectivity by Enveloped Viruses, Centralizing on EPA and DHA. Syst. Microbiol. Biomanuf. 2021, 1, 186–192. [Google Scholar] [CrossRef]
- Asbell, P.A.; Sanfilippo, C.M.; Sahm, D.F.; DeCory, H.H. Trends in Antibiotic Resistance Among Ocular Microorganisms in the United States From 2009 to 2018. JAMA Ophthalmol. 2020, 138, 439–450. [Google Scholar] [CrossRef] [PubMed]
- Selimoglu, E. Aminoglycoside-Induced Ototoxicity. Curr. Pharm. Des. 2007, 13, 119–126. [Google Scholar] [CrossRef] [PubMed]
- Gorelik, E.; Masarwa, R.; Perlman, A.; Rotshild, V.; Abbasi, M.; Muszkat, M.; Matok, I. Fluoroquinolones and Cardiovascular Risk: A Systematic Review, Meta-Analysis and Network Meta-Analysis. Drug Saf. 2019, 42, 529–538. [Google Scholar] [CrossRef]
- Muanda, F.T.; Sheehy, O.; Bérard, A. Use of Antibiotics during Pregnancy and the Risk of Major Congenital Malformations: A Population Based Cohort Study. Br. J. Clin. Pharmacol. 2017, 83, 2557–2571. [Google Scholar] [CrossRef] [PubMed]
- Colin, J. Ganciclovir Ophthalmic Gel, 0.15%: A Valuable Tool for Treating Ocular Herpes. Clin. Ophthalmol. 2007, 1, 441–453. [Google Scholar] [PubMed]

| Ophthalmic Solutions | Composition (100 mL) |
|---|---|
| Visuprime | PQ133 (100 mg), poloxamer 407 (4.500 mg), disodium EDTA (100 mg), isotonic buffered solution. |
| Oftasecur | Biosecur (2 g), hypromellose (0.15 g), phospholipids S80, boric acid, sodium tetraborate decahydrate, sodium chloride, distilled water. |
Disclaimer/Publisher’s Note: The statements, opinions and data contained in all publications are solely those of the individual author(s) and contributor(s) and not of MDPI and/or the editor(s). MDPI and/or the editor(s) disclaim responsibility for any injury to people or property resulting from any ideas, methods, instructions or products referred to in the content. |
© 2023 by the authors. Licensee MDPI, Basel, Switzerland. This article is an open access article distributed under the terms and conditions of the Creative Commons Attribution (CC BY) license (https://creativecommons.org/licenses/by/4.0/).
Share and Cite
Dell’Annunziata, F.; Morone, M.V.; Gioia, M.; Cione, F.; Galdiero, M.; Rosa, N.; Franci, G.; De Bernardo, M.; Folliero, V. Broad-Spectrum Antimicrobial Activity of Oftasecur and Visuprime Ophthalmic Solutions. Microorganisms 2023, 11, 503. https://doi.org/10.3390/microorganisms11020503
Dell’Annunziata F, Morone MV, Gioia M, Cione F, Galdiero M, Rosa N, Franci G, De Bernardo M, Folliero V. Broad-Spectrum Antimicrobial Activity of Oftasecur and Visuprime Ophthalmic Solutions. Microorganisms. 2023; 11(2):503. https://doi.org/10.3390/microorganisms11020503
Chicago/Turabian StyleDell’Annunziata, Federica, Maria Vittoria Morone, Marco Gioia, Ferdinando Cione, Massimiliano Galdiero, Nicola Rosa, Gianluigi Franci, Maddalena De Bernardo, and Veronica Folliero. 2023. "Broad-Spectrum Antimicrobial Activity of Oftasecur and Visuprime Ophthalmic Solutions" Microorganisms 11, no. 2: 503. https://doi.org/10.3390/microorganisms11020503
APA StyleDell’Annunziata, F., Morone, M. V., Gioia, M., Cione, F., Galdiero, M., Rosa, N., Franci, G., De Bernardo, M., & Folliero, V. (2023). Broad-Spectrum Antimicrobial Activity of Oftasecur and Visuprime Ophthalmic Solutions. Microorganisms, 11(2), 503. https://doi.org/10.3390/microorganisms11020503











